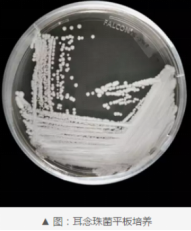

“风靡”半个美国的耳念珠菌到底是个啥?




▎本期科普作者🥼

据央视新闻客户端报道,当地时间3月20日,美国疾病控制和预防中心表示,耳念珠菌正在以“惊人的速度”传播,目前已遍布美国一半以上的州,成为紧迫的公共卫生威胁。

耳念珠菌不是细菌,而是一种真菌,2009年首次在日本患者的外耳道发现而得名。该菌属于棒孢酵母属的念珠菌分支,念珠菌临床致病的多达16种包括白色念珠菌和非白色念珠菌,其中非白念珠菌主要包括热带念珠菌、克柔念珠菌、近平滑念珠菌、耳念珠菌等。

耳念珠菌常呈多重耐药,一些菌株对现有的3类抗真菌药物均耐药,对氟康唑、两性霉素B具有内源性或者诱导性耐药。一些常用的杀毒剂不能杀灭该菌。

2009年在日本东京一名女性患者的外耳道发现该菌,并首次命名为耳念珠菌。我国2018年北京大学人民医院首次报道该菌,截止2020年8月我国公开报道的该菌有25例。据统计,除南极洲以外的六大洲三十多个国家陆续报道了耳念珠菌感染病例和医院感染暴发事件。2013年美国首次报道该菌,目前在美国流行爆发,美国疾病控制和预防中心(CDC)发布信息称“以惊人的速度”传播,已遍布美国一半以上的州,成为紧迫的公共卫生威胁。

耳念珠菌主要引起医院感染,或者爆发包括ICU的获得性感染。该菌在医院环境下具有很强的克隆传播性,可在患者和环境之间广泛传播,比如可附着于人皮肤上,不造成感染但可以传播其他人。感染耳念珠菌的高风险人群主要是免疫功能低下者或者长期患有糖尿病等有慢性疾病的患者,感染途径主要是接触被污染的物体表面或人际传播。
感染耳念珠菌的风险因素与其他念珠菌相似,包括糖尿病、老年、手术、化疗、透析患者、HIV感染者、机械通气、使用各种导管、插管以及长期使用抗细菌药物或者真菌药物等。

人体的皮肤、口腔、鼻腔、胃肠道、泌尿道等部位有无数的细菌存在,这些细菌被称为正常菌群,而念珠菌属作为共生菌同样存在人体而不具有致病性。健康人的正常菌群和真菌相互制约,彼此平衡,只有当人体免疫系统受到损害或正常菌群相互作用失调时,这些细菌或真菌才能从共生菌变成致病菌,比如一些长期使用免疫抑制剂造成免疫功能低下的人群或长期使用广谱抗生素的人才有机会感染耳念珠菌。总之对于免疫力正常的人不会感染耳念珠菌。
1. 正常人群不需要预防。
2. 手卫生是预防和控制耳念珠菌医院感染的一个非常重要的环节,医务人员应保持良好的手部卫生。
3. 耳念珠菌通过接触传播,对医院内感染和定植患者执行单间隔离。
4. 耳念珠菌在物体表面留时间可以达到数周或数月,医院内患者周围环境、高频接触的物体表面、公用的医疗器械等均有耳念珠菌污染的报道, 环境清洁和消毒在预防耳念珠菌医院感染传播中至关重要。
5. 一旦在医院内发现耳念珠菌感染的病例,应对患者、家属陪护、医务人员等密切接触者开展筛查,以检测定植和传播的潜在风险,同时做好患者、家属陪护的健康教育。
6. 提高耳念珠菌的实验室检测能力,加强抗真菌药物管理,形成完善的耳念珠菌医院感染防控方案。
综上所述,我国耳念珠菌感染属于偶发病例,且耐药性不高,尚未发现异常致病性,因此无须受美国等主要流行地区影响而过度解读目前形势。
▎策划制作📚
文中图片来源于网络,侵权立删
编辑:杨昕昕 朱萌萌
校验:陈聪
责编:吴行

▎关注我们🔍







